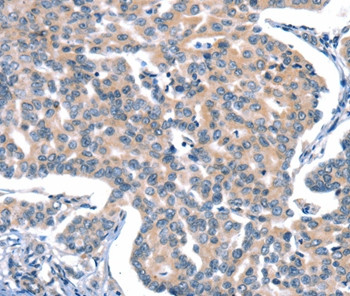
CaV2.1 Antibody in Immunohistochemistry (Paraffin) (IHC (P))

Search
Invitrogen
CaV2.1 Polyclonal Antibody
{{$productOrderCtrl.translations['antibody.pdp.commerceCard.promotion.promotions']}}
{{$productOrderCtrl.translations['antibody.pdp.commerceCard.promotion.viewpromo']}}
{{$productOrderCtrl.translations['antibody.pdp.commerceCard.promotion.promocode']}}: {{promo.promoCode}} {{promo.promoTitle}} {{promo.promoDescription}}. {{$productOrderCtrl.translations['antibody.pdp.commerceCard.promotion.learnmore']}}



Please note: We are reviewing Western blot images included in the antibody testing data in our catalog, including those provided by third parties. Unless expressly labeled or annotated as “raw-unedited”, Western blot images included in the antibody testing data in our catalog may have been edited, optimized or otherwise adjusted for presentation.
产品信息
PA5-50634
种属反应
已发表种属
宿主/亚型
分类
类型
抗原
偶联物
形式
浓度
规格
纯化类型
保存液
内含物
保存条件
运输条件
RRID
产品详细信息
The antibody detects endogenous levels of total CACNA1A protein.
靶标信息
Voltage-dependent calcium channels mediate the entry of calcium ions into excitable cells, and are also involved in a variety of calcium-dependent processes, including muscle contraction, hormone or neurotransmitter release, and gene expression. Calcium channels are multisubunit complexes composed of alpha-1, beta, alpha-2/delta, and gamma subunits. The channel activity is directed by the pore-forming alpha-1 subunit, whereas, the others act as auxiliary subunits regulating this activity. The distinctive properties of the calcium channel types are related primarily to the expression of a variety of alpha-1 isoforms, alpha-1A, B, C, D, E, and S. This gene encodes the alpha-1A subunit, which is predominantly expressed in neuronal tissue. Mutations in this gene are associated with 2 neurologic disorders, familial hemiplegic migraine and episodic ataxia 2. This gene also exhibits polymorphic variation due to n-repeats. Multiple transcript variants encoding different isoforms have been found for this gene. In one set of transcript variants, the n-repeats occur in the 3 UTR, and are not associated with any disease. But in another set of variants, an insertion extends the coding region to include the n-repeats which encode a polyglutamine tract. Expansion of the n-repeats from the normal 4-16 to 21-28 in the coding region is associated with spinocerebellar ataxia 6.
仅用于科研。不用于诊断过程。未经明确授权不得转售。
生物信息学
蛋白别名: BI; Brain calcium channel I; Calcium channel, L type, alpha-1 polypeptide isoform 4; Voltage-dependent P/Q-type calcium channel subunit alpha-1A; Voltage-gated calcium channel subunit alpha Cav2.1
基因别名: CACH4; CACN3; CACNA1A; CACNL1A4
Entrez Gene ID: (Human) 773